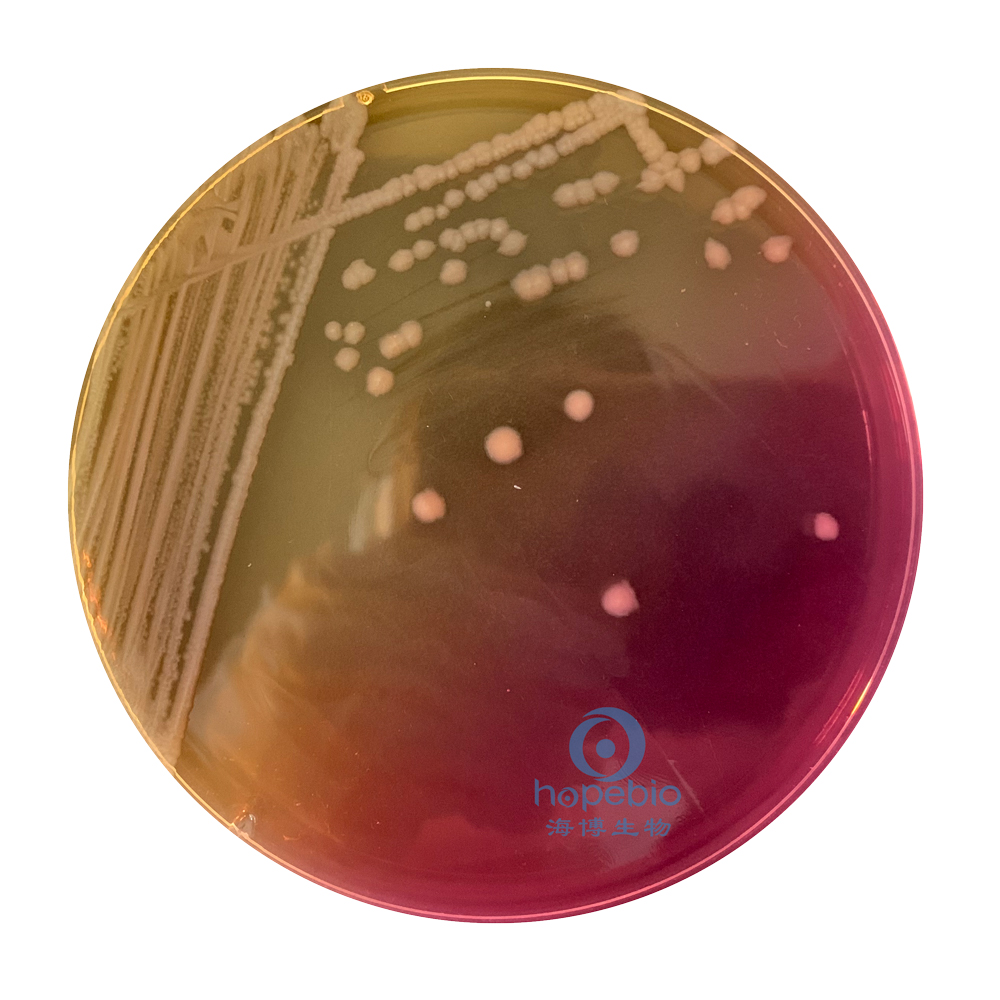
普通变形杆菌有哪些,为什么奇异变形杆菌那么难治

一、参考标准
《SN/T 2552.8-2010 乳及乳制品卫生微生物学检验方法 第8部分:普通变形杆菌和奇异变形杆菌检验》
二、生物学特性
变形杆菌为能活泼运动而又极为多形性的一群肠道菌,有球形和丝状形,具有鞭毛、无荚膜、无芽胞、革兰氏阴性,运动活泼。在固体培养基上呈扩散生长,形成迁徙生长现象。
三、检验程序

图1 普通变形杆菌和奇异变形杆菌检验程序
四、检验方法和结果
1、选择性增菌
普通变形杆菌和奇异变形杆菌在GN增菌液中36℃±1℃培养18-24h后生长浑浊,如图2所示:

a:空白对照;b:普通变形杆菌;c:奇异变形杆菌 图2 GN增菌液的培养结果
2、初步生化鉴定
①SS琼脂试验
取增菌液1环,划线接种于SS平板上,于36℃±1℃培养18-24h,普通变形杆菌和奇异变形杆菌在SS平板上的典型菌落为:1mm-2mm大小、无色半透明或有黑色中心,边缘整齐,表面光滑的圆形菌落,如下图所示:
a:奇异变形杆菌 |
b:普通变形杆菌 |
②克氏双糖培养基试验
挑取SS平板上的可疑菌落,穿刺接种混合克氏双糖铁斜面,接种时先在斜面划线,然后再穿刺到底层放入培养箱36℃±1℃培养18-24h,普通变形杆菌和奇异变形杆菌的试验现象为:斜面红/底层黄(部分区域黑色),发酵葡萄糖但不发酵乳糖同时产生硫化氢和产气,如图3所示。
注意:能产生硫化氢的菌应及时观察试验结果,以免生成的硫化铁形成黑色区域,遮盖斜面与底层的颜色影响判断结果。

a:空白对照;b:普通变形杆菌;c:奇异变形杆菌 图3 克氏双糖的培养结果
③尿素琼脂试验
挑取SS平板上的可疑菌落,穿刺接种尿素琼脂斜面,接种时先在斜面划线,然后再穿刺到底层放入培养箱36℃±1℃培养18-24h,普通变形杆菌和奇异变形杆菌的试验现象为尿素培养基变玫红,如图4所示:

空白对照;b:普通变形杆菌;c:奇异变形杆菌 图4 尿素培养基的培养结果
④苯丙氨酸脱氨酶培养基试验
挑取SS平板上的可疑菌落,接种在苯丙氨酸脱氨酶培养基斜面划线,然后放入培养箱36℃±1℃培养18-24h,培养结束后滴加4-5滴苯丙氨酸指示剂,使其覆盖培养基表面,1min-5min呈现绿色则为阳性,如图5所示:

a:空白对照;b:普通变形杆菌;c:奇异变形杆菌 图5 苯丙氨酸脱氨酶培养基的培养结果
3、进一步的生化鉴定
符合上一步要求的可疑菌落需进一步进行其他生化试验。
①靛基质试验
将菌接种于胰蛋白水培养基中,放入培养箱36℃±1℃培养18-24h,滴加Kovacs氏靛基质试剂,立即观察反应结果。普通变形杆菌为玫红色环,为阳性;奇异变形杆菌为黄色环,为阴性,如图6所示:

a:空白对照;b:奇异变形杆菌;c:普通变形杆菌; 图6 靛基质的培养结果
②鸟氨酸脱羧酶试验
将菌接种于鸟氨酸脱羧酶生化管中,加无菌液体石蜡覆盖培养基液体表面,放入培养箱36℃±1℃培养18-24h,接种普通变形杆菌的培养基呈阴性,培养基变黄;接种奇异变形杆菌的培养基呈阳性,培养基为紫色,如图7所示:

a:空白对照;b:奇异变形杆菌;c:普通变形杆菌 图7 鸟氨酸脱羧酶的培养结果
③甘露醇试验
将菌接种于鸟氨酸脱羧酶生化管中,放入培养箱36℃±1℃培养18-24h,接种奇异变形杆菌和普通变形杆菌的培养基都呈阴性,培养基颜色为蓝色或蓝绿色,如图8所示:

a:空白对照;b:奇异变形杆菌;c:普通变形杆菌 图8 甘露醇的培养结果
④氧化酶试验
变形杆菌氧化酶试验不变色,为阴性,铜绿假单胞菌为阳性变蓝,如图9所示:

a:铜绿假单胞菌10104;b:奇异变形杆菌 图9 鸟氨酸脱羧酶的培养结果
普通变形杆菌和奇异变形杆菌生化鉴定表:

注:本文属海博生物原创,未经允许不得转载。